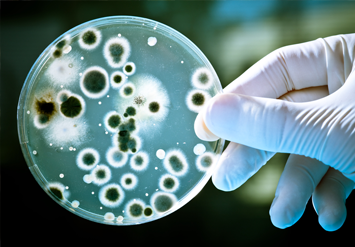

Черника
в домашних условиях
круглый год!
- Полезно
- Вкусно
- Выгодно
ягоды дома круглый год




Чтобы вы наслаждались черникой из домашней ягодницы «Ягодный урожай» мы объединили вместе:

Джунгли Амазонии, часть которых расположены в Эквадоре, это уникальное место на Земле. Растения, которые там растут, в 2-3 раза крупнее своих аналогов из других мест.

Ученые РАН под руководством академика Астафьева А. С. 5 лет провели в Эквадоре, изучая этот единственный в своем роде феномен, и научно доказали, что все дело в составе почвы.

За это открытие они были номинированы на Нобелевскую премию, а вы получили возможность пользоваться его плодами.

Это гибридный сорт, который появился совсем недавно.

Чернике он дает большую, красивую , с повышенным содержанием витаминов и микроэлементов.

Данный сорт обладает очень высокой урожайностью!

Для защиты и ускорения роста, почва и саженецы черники обогащаются на молекулярном уровне путем прямого впрыскивания.

Семена под высоким давлением обработаны новейшим биостимулятором роста.

Он не только ускоряет созревание ягод и продлевает срок жизни черники, но еще и защищает ее от всех известных болезней, которые могут ей навредить..

Джунгли Амазонии, часть которых расположены в Эквадоре, это уникальное место на Земле. Растения, которые там растут, в 2-3 раза крупнее своих аналогов из других мест.

Ученые РАН под руководством академика Астафьева А. С. 5 лет провели в Эквадоре, изучая этот единственный в своем роде феномен, и научно доказали, что все дело в составе почвы.

За это открытие они были номинированы на Нобелевскую премию, а вы получили возможность пользоваться его плодами.

Это гибридный сорт, который появился совсем недавно.

Чернике он дает большую, красивую , с повышенным содержанием витаминов и микроэлементов.

Данный сорт обладает очень высокой урожайностью!

Для защиты и ускорения роста, почва и саженецы черники обогащаются на молекулярном уровне путем прямого впрыскивания.

Саженцы под высоким давлением обработаны новейшим биостимулятором роста.
Он не только ускоряет созревание ягод и продлевает срок жизни черники, но еще и защищает ее от всех известных болезней, которые могут ей навредить..
(содержит железо, магний, калий, кальций, натрий, фосфор, кремний, цинк и медь) и витаминов (А, В, С и других).

улучшает зрение, укрепляет память, ускоряет обменные процессы в организме.
избавляет женщин
от целлюлита:
мелкие косточки ягоды
стимулируют кровообращение
в проблемных зонах.
отбеливает кожу, повышает ее упругость и эластичность.
незаменима для нормализации работы женской репродуктивной системы.
Каждая ягодка из домашней ягодницы «Ягодный урожай» это ваши крепкое здоровье и неувядающая красота!

Домашняя ягодница «Ягодный урожай» производятся под надзором Российской академии наук. Это гарантирует, что вы получаете натуральный, экологически чистый продукт. Сертифицировано в соответствии со стандартами РФ.
Наш интернет-магазин уважительно относится к правам клиента. Соблюдается строгая конфиденциальность при оформлении заказа. Сведения надёжно сохраняются и защищены от передачи.
Согласием на обработку данных клиента исключительно с целью оказания услуг является размещение заказа на сайте.
К персональным данным относится личная информация о клиенте: домашний адрес; имя, фамилия, отчество; сведения о рождении; имущественное, семейное положение; личные контакты (телефон, электронная почта) и прочие сведения, которые перечислены в Законе РФ № 152-ФЗ «О персональных данных» от 27 июля 2006 г.
Клиент вправе отказаться от обработки персональных данных. Нами в данном случае гарантируется удаление с сайта всех персональных данных в трёхдневный срок в рабочее время. Подобный отказ клиент может оформить простым электронным письмом на адрес [email protected].
Настоящее пользовательское соглашение заключается между Вами – Клиентом, Рекламодателем и СРА - сетью.
Клиент – лицо, которое посредством деятельности CPA-сети, привлекаемое методами продвижения, на приобретение/отчуждение оферов на товары и/или услуги, предлагаемые Рекламодателем, имеющие намерение заказать или приобрести либо заказывающий, приобретающий или использующий товары исключительно для личных, семейных, домашних и иных нужд, не связанных с осуществлением предпринимательской деятельности.
Рекламодатель – лицо, которое желает разместить офер в CPA-сети, с целью отчуждения определенного товара и/или услуги.
CPA-сеть (сокращение от Cost Per Action, то есть оплата за действие) – электронная среда деловой активности, в процессе которой между Рекламодателем и СРА-сетью складываются договорные взаимоотношения, в силу которых, Рекламодатель предлагает оферы на товар и/или услугу, а СРА-сеть, в свою очередь, привлекает клиентов, заинтересованных в приобретении оферов, разрешёнными Рекламодателем методами. Конечным результатом такой активности, является приобретение товара и/или услуги Клиентом, посредством CPA-сети.
Стороны – Клиент, Рекламодатель, CPA-сеть.
Сайт – интернет ресурс интернет-магазина, имеющий доменное имя a-low-blueberries-home.health-new.org, пребывающий под организационным управлением и принадлежащий Рекламодателю, на условиях права частной собственности.
Публичная оферта – адресованное администрацией неопределенному кругу лиц или нескольким конкретным лицам предложение, которое определенно, конкретно и выражает намерение лица, сделавшего предложение, считать себя заключившим данное пользовательское соглашение с адресатом, которым будет принято предложение.
Акцепт – полное принятие одной из Сторон условий публичной оферты СРА-сети на заключение данного пользовательского соглашения. Акцептированием публичной оферты происходит в момент начала пользования Сайтом (в том числе в ознакомительных целях) и его сервисами (услугами).
1. Общие положения
1.1. Настоящее Пользовательское соглашение (далее по тексту – «Соглашение») определяет общие правила посещения, использования сервисов и нормы общего поведения на Сайте Клиентом и регулирует гражданско-правовые взаимоотношения, которые складываются между Клиентом и Рекламодателем, а так же Клиентом, Рекламодателем и СРА-сетью в процессе их взаимодействия.
1.2. Настоящее Соглашение может быть изменено по решению CPA-сети и/или Рекламодателя, в одностороннем порядке. CPA-сеть и/или Рекламодатель не несет обязательства личного уведомления Клиента о таких изменениях. Новая редакция Соглашения вступает в силу, с момента приобретения товара/услуги Рекламодателя Клиентом.
1.3. Условия Соглашения распространяются на всех Клиентов сайта, без исключений.
1.4. Клиент, начиная пользоваться Сайтом, подтверждает факт того, что ознакомился с положениями настоящего Соглашения в здравом уме и при ясной памяти, понимает их в полной мере и принимает условия пользования Сайтом в полной мере. При несогласии с положениями настоящего Соглашения (частично или в целом), лицо, выразившее такую волю, не имеет право пользоваться информационным полем Сайта.
2. Регуляция взаимодействия сторон
2.1. Реализация предоставленных Сайтом услуг и (или) возможностей не предоставляет Клиенту каких-либо исключительных прав и привилегий.
2.2. Стороны настоящего Соглашения достигли согласия о том, что СРА-сеть вправе размещать на Сайте рекламные блоки, баннеры, объявления в любых его областях, в том числе там, где размещается информация опубликованная Клиентом, без дополнительного согласия Клиента.
2.3. Информация, размещаемая на Сайте СРА-сетью, является результатом интеллектуальной деятельности СРА-сети и все имущественные и личные неимущественные права на такую информацию, принадлежат СРА-сети, до тех пор, пока не будет установлено иное. При этом у Клиента не возникает, каких-либо исключительных прав на результат интеллектуальной деятельности СРА-сети, выраженной в графической, текстовой, аудио-видео форме, размещаемой СРА-сетью на Сайте.
2.4. СРА-сеть не несет обязательств по защите нарушенных прав Клиента, в контексте урегулирования возникших на этой почве споров, в том числе, в судебном порядке.
2.5. СРА-сеть не является владельцем/изготовителем товаров и/или услуг, размещаемых на Сайте и не несет ответственности за нарушение прав Клиента. Целью СРА-сети по настоящему Соглашению является привлечение потенциальных клиентов, заинтересованных в приобретении товаров и/или услуг, разрешёнными Рекламодателем методами. Конечным результатом такой активности, является приобретение товара и/или услуги Клиентом, посредством CPA-сети.
2.6. Нарушение Клиентом или Рекламодателем авторских прав, принадлежащих СРА-сети и (или) другим лицам, влечет для нарушителя ответственность, предусмотренную положениями действующего законодательства Российской Федерации.
2.7. В случае выявления нарушения авторских прав Клиентом, путем незаконного размещения не принадлежащих Клиенту материалов, СРА-сеть изымает из свободного доступа такие материалы, по первому требованию законного правообладателя.
2.8. Клиенту запрещается размещать на Сайте информацию, которая прямо, или косвенно содержит в себе общепринятые признаки порнографии, оскорбляющую, ущемляющую, наносящую ущерб чьему-либо достоинству, содержащую призывы к насилию, бесчинству и другим действиям, влекущим нарушения норм действующего законодательства, определенной территориальной юрисдикции, содержащую вредоносное программное обеспечение и (или) другую информацию, которая может принести вред третьим лицам.
2.9. В случае нарушения условий п. 2.8. настоящего Соглашения и невыполнения требований СРА-сети, в том числе по изъятию такой информацию из публичного доступа, Клиенты Сайта несут ответственность, предусмотренную положениями настоящего Соглашения и(или) действующего законодательства Российской Федерации. СРА-сеть в таком случае, имеет право убрать упомянутую в п. 2.8. информацию самостоятельно.
2.10. СРА-сеть не несет ответственности за результаты посещения Клиентом сторонних (внешних) ресурсов, ссылки на которые могут быть размещены на Сайте. Под результатами понимается любой результат вне зависимости от его характера, а также тот, от наступления которого Клиент понес какие-либо материальные убытки, моральный ущерб и другие негативные проявления.
2.11. Порядок ведения торговли дистанционным путем, права и обязанности Сторон соглашения, а также третьих лиц, особые требования к процессам взаимодействия Сторон и оформления рекламных площадок, регулируются в нормативном порядке – Федеральным Законом «О Рекламе», Правилами ведения торговли дистанционным путем, утвержденными Постановлением Правительства Российской Федерации №612 от 27.09.2007, а так же другими нормативными актами и настоящим Соглашением.
3. Права и обязанности Рекламодателя
3.1. Рекламодатель обязан предложить Клиенту услуги по доставке товаров путем их пересылки почтовыми отправлениями или перевозки с указанием используемого способа доставки и вида транспорта.
3.2. Рекламодатель обязан сообщить Клиенту о необходимости использования квалифицированных специалистов по подключению, наладке и пуску в эксплуатацию технически сложных товаров, которые по техническим требованиям не могут быть пущены в эксплуатацию без участия соответствующих специалистов.
3.3. Рекламодатель не вправе без согласия Клиента выполнять дополнительные работы (оказывать услуги) за плату.
3.4. Рекламодатель обязан до заключения договора розничной купли-продажи (далее – «Договор») предоставить Клиенту информацию об основных потребительских свойствах товара и адресе (месте нахождения) Рекламодателя, о месте изготовления товара, полном фирменном наименовании (наименовании) Рекламодателя, о цене и об условиях приобретения товара, о его доставке, сроке службы, сроке годности и гарантийном сроке, о порядке оплаты товара, а также о сроке, в течение которого действует предложение о заключении Договора.
3.5. Рекламодатель в момент доставки товара обязан довести до сведения Клиента в письменной форме следующую информацию (для импортных товаров - на русском языке):
3.5.1. наименование технического регламента или иное обозначение, установленное законодательством Российской Федерации о техническом регулировании и свидетельствующее об обязательном подтверждении соответствия товара;
3.5.2. сведения об основных потребительских свойствах товара (работ, услуг), а в отношении продуктов питания - сведения о составе (в том числе наименование использованных в процессе изготовления продуктов питания пищевых добавок, биологически активных добавок, информация о наличии в продуктах питания компонентов, полученных с применением генно-инженерно-модифицированных организмов), пищевой ценности, назначении, об условиях применения и хранения продуктов питания, о способах изготовления готовых блюд, весе (объеме), дате и месте изготовления и упаковки (расфасовки) продуктов питания, а также сведения о противопоказаниях для их применения при отдельных заболеваниях;
3.5.3. цена в рублях и условия приобретения товара (выполнения работ, оказания услуг);
3.5.4. сведения о гарантийном сроке, если он установлен;
3.5.5. правила и условия эффективного и безопасного использования товаров;
3.5.6. сведения о сроке службы или сроке годности товаров, а также сведения о необходимых действиях Клиента по истечении указанных сроков и возможных последствиях при невыполнении таких действий, если товары по истечении указанных сроков представляют опасность для жизни, здоровья и имущества Клиента или становятся непригодными для использования по назначению;
3.5.7. место нахождения (адрес), фирменное наименование (наименование) изготовителя (Рекламодателя), место нахождения (адрес) организации (организаций), уполномоченной изготовителем (Рекламодателем) на принятие претензий от Клиента и производящей ремонт и техническое обслуживание товара, для импортного товара - наименование страны происхождения товара; (см. текст в предыдущей редакции)
3.5.8. сведения об обязательном подтверждении соответствия товаров (услуг) обязательным требованиям, обеспечивающим их безопасность для жизни, здоровья Клиента, окружающей среды и предотвращение причинения вреда имуществу Клиента в соответствии с законодательством Российской Федерации;
3.5.9. сведения о правилах продажи товаров (выполнения работ, оказания услуг);
3.5.10. сведения о конкретном лице, которое будет выполнять работу (оказывать услугу), и информация о нем, если это имеет значение исходя из характера работы (услуги);
3.5.11 информация об энергетической эффективности товаров, в отношении которых требование о наличии такой информации определено в соответствии с законодательством Российской Федерации об энергосбережении и о повышении энергетической эффективности.
3.6. Рекламодатель обязан предоставить информацию Клиенту, если приобретаемый Клиентом товар был в употреблении или в нем устранялся недостаток (недостатки).
3.7. Рекламодатель обязан проинформировать Клиента о товаре, включая условия его эксплуатации и правила хранения, доводится до Клиента путем размещения на товаре, на электронных носителях, прикладываемых к товару, в самом товаре (на электронной плате внутри товара в разделе меню), на таре, упаковке, ярлыке, этикетке, в технической документации или иным способом, установленным законодательством Российской Федерации.
3.8. Рекламодатель обязан информировать Клиента о сроке, в течение которого действует предложение о продаже товара/услуги на Сайте.
3.9. Рекламодатель имеет право как принять, так и отклонить предложение Клиента о пересылке товаров почтовым отправлением в адрес "До востребования".
3.10. Рекламодатель обязан обеспечивать конфиденциальность персональных данных о Клиенте в соответствии с законодательством Российской Федерации в области персональных данных.
3.11. Рекламодатель предоставляет Клиенту каталоги, буклеты, проспекты, фотографии или другие информационные материалы, содержащие полную, достоверную и доступную информацию, характеризующую предлагаемый товар.
3.12. При отказе Клиента от товара Рекламодатель обязан возвратить ему сумму, уплаченную Клиентом в соответствии с Договором, за исключением расходов Рекламодателя на доставку от Клиента возвращенного товара, не позднее чем через 10 дней с даты предъявления Клиентом соответствующего требования.
3.13. В случае если Договор заключен с условием о доставке товара Клиенту, Рекламодатель обязан в установленный Договором срок доставить товар в место, указанное Клиентом, а если место доставки товара Клиентом не указано, то в место его жительства.
3.14. Рекламодатель обязан передать товар Клиенту в порядке и сроки, которые установлены в Договоре.
3.15. Рекламодатель обязан передать Клиенту товар, качество которого соответствует Договору и информации, представленной Клиенту при заключении Договора, а также информации, доведенной до его сведения при передаче товара (в технической документации, прилагаемой к товару, на этикетках, путем нанесения маркировки либо иными способами, предусмотренными для отдельных видов товаров).
3.16. Если Рекламодатель при заключении Договора был поставлен Клиентом в известность о конкретных целях приобретения товара, Рекламодатель обязан передать Клиенту товар, пригодный для использования в соответствии с этими целями.
3.17. Расходы на осуществление возврата суммы, уплаченной Клиентом в соответствии с Договором, несет Рекламодатель.
3.18. Оплата товара Клиентом путем перевода средств на счет третьего лица, указанного Рекламодателем, не освобождает Рекламодателя от обязанности осуществить возврат уплаченной Клиентом суммы при возврате Клиентом товара как надлежащего, так и ненадлежащего качества.
4. Права и обязанности Клиента
4.1. Клиент вправе отказаться от товара в любое время до его передачи, а после передачи товара - в течение 7 дней.
4.2. Клиент вправе отказаться от товара в течение 3 месяцев с момента передачи товара, в случае если информация о порядке и сроках возврата товара надлежащего качества не была предоставлена в письменной форме в момент доставки товара.
4.3. Возврат товара надлежащего качества возможен в случае, если сохранены его товарный вид, потребительские свойства, а также документ, подтверждающий факт и условия покупки указанного товара. Отсутствие у Клиента указанного документа не лишает его возможности ссылаться на другие доказательства приобретения товара у данного Рекламодателя.
4.4. Клиент не вправе отказаться от товара надлежащего качества, имеющего индивидуально-определенные свойства, если указанный товар может быть использован исключительно приобретающим его Клиентом.
4.5. Клиент обязан повторно оплатить стоимость услуг по доставке товара, в случае если доставка товара произведена в установленные Договором сроки, но товар не был передан Клиенту по его вине, последующая доставка производится в новые сроки, согласованные с Рекламодателем.
4.6. В случае если Клиенту передается товар с нарушением условий Договора, касающихся количества, ассортимента, качества, комплектности, тары и (или) упаковки товара, Клиент может не позднее 20 дней после получения товара известить Рекламодателя об этих нарушениях.
4.7. Если обнаружены недостатки товара, в отношении которого гарантийные сроки или сроки годности не установлены, Клиент вправе предъявить требования в отношении недостатков товара в разумный срок, но в пределах 2 лет со дня передачи его Клиенту, если более длительные сроки не установлены нормативными актами или Договором.
4.8. Клиент вправе предъявить требования к Рекламодателю в отношении недостатков товара, если они обнаружены в течение гарантийного срока или срока годности.
4.9. Клиент, которому продан товар ненадлежащего качества, если это не было оговорено Рекламодателем, вправе по своему выбору потребовать:
а) безвозмездного устранения недостатков товара или возмещения расходов на их исправление Клиентом или третьим лицом;
б) соразмерного уменьшения покупной цены;
в) замены на товар аналогичной марки (модели, артикула) или на такой же товар другой марки (модели, артикула) с соответствующим перерасчетом покупной цены. При этом в отношении технически сложных и дорогостоящих товаров эти требования Клиента подлежат удовлетворению в случае обнаружения существенных недостатков.
4.10. Клиент вместо предъявления требований, указанных в пункте 4.9 настоящего Соглашения, вправе отказаться от исполнения Договора и потребовать возврата уплаченной за приобретенный товар суммы. По требованию Рекламодателя и за его счет Клиент должен возвратить товар с недостатками.
4.11. Клиент вправе потребовать полного возмещения убытков, причиненных ему вследствие продажи товара ненадлежащего качества. Убытки возмещаются в сроки, установленные Законом Российской Федерации "О защите прав потребителей" для удовлетворения соответствующих требований Клиента.
4.12. Клиент вправе отказаться от исполнения Договора и потребовать возмещения причиненных убытков, при отказе Рекламодателя передать товар.
4.13. При возврате товара ненадлежащего качества отсутствие у Клиента документа, подтверждающего факт и условия покупки товара, не лишает его возможности ссылаться на другие доказательства приобретения товара у Рекламодателя.
4.14. Отказ или уклонение Рекламодателя от составления накладной или акта не лишают Клиента права требовать возврата товара и (или) возврата суммы, уплаченной Клиентом в соответствии с Договором.
4.15. Клиент вправе отказаться от оплаты дополнительных работ (услуг), которые не оговоренные Договором, а если они оплачены, Клиент вправе потребовать от Рекламодателя возврата уплаченной сверх указанной суммы.
4.16. В случае использования результатов интеллектуальной собственности СРА-сети - материалов Сайта, в любых целях, Клиент обязан предварительно, перед размещением таких материалов, получить на это разрешение СРА-сети. При наличии разрешения СРА-сети, Клиент обязан отобразить полное название и доменное имя источника в следующем формате: интернет-магазин a-low-blueberries-home.health-new.org. Гиперссылка должна являться активной и прямой, при нажатии на которую осуществляется переход на конкретную страницу Сайта, с которой заимствован материал.
4.17. По аналогии с инструкциями, изложенными в п. 4.16. настоящего Соглашения, Клиент обязуется действовать, в случае использования результатов интеллектуальной собственности, что принадлежать третьим лицам. Способ и порядок осуществления уточняется в процессе переговоров с правообладателем материалов.
5. Ответственность сторон
5.1. СРА-сеть не несет ответственности за действия Клиента, которые повлекли нарушение прав третьих лиц, кроме случаев определенных действующим законодательством Российской Федерации.
5.2. СРА-сеть не несет ответственности за содержание информации, размещенной Рекламодателем и/или Клиентом.
5.3. СРА-сеть не несет ответственности за содержание отзывов Клиентов Сайта. Отзывы Клиентов Сайта являются субъективными мнениями их авторов, никоим образом не претендующими на объективность. Они могут не совпадать с общественным мнением и не соответствовать действительности.
5.4. Решение о выдаче/не выдаче персональных данных, принимается СРА-сетью, лишь на основании запроса, посланного лицом СРА-сети, в установленном нормами действующего законодательства порядке.
5.5. СРА-сеть вправе не реагировать на запросы, обращения и письма, что не содержат реквизитов обращающегося (ФИО, контактные данные).
5.6. СРА-сеть не несет ответственности за регистрационные данные, что были указаны Клиентом при взаимодействии с информационным полем Сайта.
5.7. СРА-сеть имеет право, без объяснения причин ограничить, блокировать доступ Клиента (в т.ч. незарегистрированного) на Сайт, с частичным, или полным удалением информации, что была размещена Клиентом на Сайте. СРА-сеть обязуется рассмотреть претензию, оформленную в порядке предусмотренном разделом 5 соглашения, в течении 30 (тридцати) календарных дней с даты ее получения.
6. Порядок урегулирования споров
6.1. В случае выявления на Сайте размещенной информации, содержащей в себе результаты интеллектуальной собственности, принадлежащие третьим лицам, правообладатель обязан:
6.1.1. Составить претензию с указанием фактических и нормативных оснований, которые дают возможность СРА-сети изъять информацию из публичного доступа.
6.1.2. Прикрепить к претензии доказательства оригинальности результата интеллектуальной собственности (оригинальный экземпляр, другие документы, подтверждающие правообладание на объект авторского права).
6.1.3. Отправить пакет документов, упомянутых в положениях п.п. 6.1.1., 6.1.2. настоящего Соглашения, на электронный почтовый ящик СРА-сети: [email protected]
6.2. Претензии Клиента по качеству обслуживания, продукции, а так же другие замечания, следует отправлять Рекламодателю на электронный почтовый ящик: [email protected]
7. Прочие условия
7.1. Все возможные ситуации, споры, вытекающие из взаимоотношений Клиента и Рекламодателя, а так же Клиента, Рекламодателя и СРА-сети, не урегулированные этим Соглашением, решаются в порядке, определенном нормами действующего законодательства Российской Федерации.
7.2. Стороны по настоящему Соглашению осознают объем прав и обязанностей, порожденных взаимоотношениями лиц, упомянутых этим Соглашением, и в полной мере отдают отчет своим действиям, понимая юридическую природу последствий таких действий, в полной мере.
7.3. Бездействие со стороны СРА-сети в случае нарушения кем-либо из Клиентов положений Соглашения, не лишает СРА-сети права предпринять позднее соответствующие действия в защиту своих интересов и защиту охраняемых законом прав.
7.4. Контактные данные Рекламодателя:
Это действительно чудо! Черника круглый год! У меня уже кустик дал четвертый урожай (как и написано – каждые 2 недели родит), черника просто объедение.
Мои внуки не нарадуются, стали чаще ко мне ходить, знают, что у меня теперь всегда есть для них вкусненькое.
Я купила вашу ягодницу, потому что для лица хочу делать черничные маски – они питают и омолаживают кожу.
Куст растет нормально, урожай стабильный. Претензий нет. И теперь у меня есть свой постоянный поставщик очень дешевой, качественной черники! Благодарю Вас!
Я купила 2 ягодницы для своих детей. Черника это лучше, чем витамины из аптеки. Гораздо полезнее.
Черничка растет и плодоносит очень хорошо. Я довольна, спасибо вам от моих деток!
Это действительно чудо! Черника круглый год! У меня уже кустик дал четвертый урожай (как и написано – каждые 2 недели родит), черника просто объедение.
Мои внуки не нарадуются, стали чаще ко мне ходить, знают, что у меня теперь всегда есть для них вкусненькое.
Я купила вашу ягодницу, потому что для лица хочу делать черничные маски – они питают и омолаживают кожу.
Куст растет нормально, урожай стабильный. Претензий нет. И теперь у меня есть свой постоянный поставщик очень дешевой, качественной черники! Благодарю Вас!
Я купила 2 ягодницы для своих детей. Черника это лучше, чем витамины из аптеки. Гораздо полезнее.
Черничка растет и плодоносит очень хорошо. Я довольна, спасибо вам от моих деток!